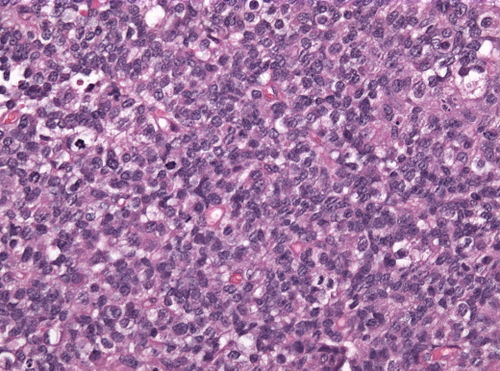
Neuropathology case IV 02.jpg

Provided clinical history
8 month old drowsy child, emergency surgery
Site
Cerebellum
Primary image
Low magnification. H&E stain.
Intermediate magnification
|
|
Intermediate magnification. H&E stain.
|
High magnification
|
|
High magnification. H&E stain.
|
Differential diagnosis
Differential diagnosis
|
|
Medulloblastoma, Ewing sarcoma/PNET, AT/RT, small cell glioblastoma
|
Additional tests
More history
More history
|
|
Vomiting since three weeks
|
Ask a colleague
Ask a colleague
|
|
A malignant small round blue tumor in the cerebellum. We need some special stains.
|
Stains
| Alcian blue/PAS to Bilirubin |
|---|
| Test | Result |
|---|
| Alcian blue/PAS | Dr Torres would ask why! |
| Alican blue pH 1.0 | Dr Torres would ask why! |
| Alcian blue pH 2.5 | Dr Torres would ask why! |
| Auramine | Dr Torres would ask why! |
| Bielchowsky | Dr Torres would ask why! |
| Bilirubin | Dr Torres would ask why! |
|
|---|
|
| Colloidal iron to Fontana-Masson |
|---|
| Test | Result |
|---|
| Colloidal iron | Dr Torres would ask why! |
| Congo red | Dr Torres would ask why! |
| Cresyl violet | Dr Torres would ask why! |
| Dieterle | Dr Torres would ask why! |
| Diff Quik | Dr Torres would ask why! |
| Fontana-Masson | Dr Torres would ask why! |
|
|---|
|
| Gallyas to Gremelius |
|---|
| Test | Result |
|---|
| Gallyas | Dr Torres would ask why! |
| Giemsa | Dr Torres would ask why! |
| GMS | Dr Torres would ask why! |
| Gomori's trichrome | Dr Torres would ask why! |
| Gram | Dr Torres would ask why! |
| Gremelius | Dr Torres would ask why! |
|
|---|
|
| JMS to Mucicarmine |
|---|
| Test | Result |
|---|
| JMS | Dr Torres would ask why! |
| Jones | Dr Torres would ask why! |
| Kinyoun | Dr Torres would ask why! |
| Luxol fast blue | Dr Torres would ask why! |
| Masson trichrome | Dr Torres would ask why! |
| M-MAS | Dr Torres would ask why! |
| Movat | Dr Torres would ask why! |
| Mucicarmine | Dr Torres would ask why! |
|
|---|
|
| Oil red O to Prussian blue |
|---|
| Test | Result |
|---|
| Oil red O | Dr Torres would ask why! |
| Orecein | Dr Torres would ask why! |
| PAS | Dr Torres would ask why! |
| PASD | Dr Torres would ask why! |
| PASF | Dr Torres would ask why! |
| PTAH | Dr Torres would ask why! |
| Prussian blue | Dr Torres would ask why! |
|
|---|
|
| Reticulin to Ziehl-Neelsen |
|---|
| Test | Result |
|---|
| Reticulin | Dr Torres would ask why! |
| Sudan black B | Dr Torres would ask why! |
| Toluidine blue | Dr Torres would ask why! |
| Verhoeff | Dr Torres would ask why! |
| Von Kossa | Dr Torres would ask why! |
| Warthin-Starry | Dr Torres would ask why! |
| Ziehl-Neeslen | Dr Torres would ask why! |
|
|---|
|
IHC
| Alpha-1 AT to Cathepsin K |
|---|
| Test | Result |
|---|
| alpha-1 AT | Dr Torres would ask why! |
| ACTH | Dr Torres would ask why! |
| AE1/AE1 | POSITIVE |
| alpha-fetoprotein | Dr Torres would ask why! |
| Alk-I | Dr Torres would ask why! |
| AMACR | Dr Torres would ask why! |
| AR | Dr Torres would ask why! |
| ATRX | Dr Torres would ask why! |
| Beta2-microglobulin | Dr Torres would ask why! |
| B72.3 | Dr Torres would ask why! |
| Beta-catenin | Dr Torres would ask why! |
| BCL2 | Dr Torres would ask why! |
| BCL6 | Dr Torres would ask why! |
| BCLxL | Dr Torres would ask why! |
| C3 comp | Dr Torres would ask why! |
| CA9 | Dr Torres would ask why! |
| Calcitonin | Dr Torres would ask why! |
| Calponin | Dr Torres would ask why! |
| Calretinin | Dr Torres would ask why! |
| CAM5.2 | Dr Torres would ask why! |
| Cathepsin K | Dr Torres would ask why! |
|
|---|
|
| CD10 to Chromogranin |
|---|
| Test | Result |
|---|
| CD10 | Dr Torres would ask why! |
| CD117 | Dr Torres would ask why! |
| CD138 | Dr Torres would ask why! |
| CD15 | Dr Torres would ask why! |
| CD1a | Dr Torres would ask why! |
| CD20 | Dr Torres would ask why! |
| CD21 | Dr Torres would ask why! |
| CD23 | Dr Torres would ask why! |
| CD3 | Dr Torres would ask why! |
| CD30 | Dr Torres would ask why! |
| CD31 | Dr Torres would ask why! |
| CD34 | Dr Torres would ask why! |
| CD35 | Dr Torres would ask why! |
| CD4 | Dr Torres would ask why! |
| CD43 | Dr Torres would ask why! |
| CD45 (LCA) | NEGATIVE |
| CD5 | Dr Torres would ask why! |
| CD56 | POSITIVE |
| CD57 | Dr Torres would ask why! |
| CD68 | Dr Torres would ask why! |
| CD7 | Dr Torres would ask why! |
| CD79a | Dr Torres would ask why! |
| CD8 | Dr Torres would ask why! |
| CD99 | WEAKLY POSITIVE |
| CDX2 | Dr Torres would ask why! |
| CEA-m | Dr Torres would ask why! |
| Chromogranin | WEAKLY POSITIVE |
|
|---|
|
| CK17 to Glypican 3 |
|---|
| Test | Result |
|---|
| CK17 | Dr Torres would ask why! |
| CK19 | Dr Torres would ask why! |
| CK20 | Dr Torres would ask why! |
| CK34betaE12 | Dr Torres would ask why! |
| CK5/6 | Dr Torres would ask why! |
| CK7 | Dr Torres would ask why! |
| CMV | Dr Torres would ask why! |
| c-MYC | Dr Torres would ask why! |
| Cyclin D1 | Dr Torres would ask why! |
| D2-40 | Dr Torres would ask why! |
| Desmin | Dr Torres would ask why! |
| DOG1 | Dr Torres would ask why! |
| EBV | Dr Torres would ask why! |
| EMA | POSITIVE |
| ER and PR | Dr Torres would ask why! |
| Factor VIII | Dr Torres would ask why! |
| Factor XIIIa | Dr Torres would ask why! |
| Fascin | Dr Torres would ask why! |
| FH | Dr Torres would ask why! |
| FSH | Dr Torres would ask why! |
| Gastrin | Dr Torres would ask why! |
| GATA3 | Dr Torres would ask why! |
| GCDFP-15 (BRST2) | Dr Torres would ask why! |
| GFAP | POSITIVE |
| GH | Dr Torres would ask why! |
| Glucagon | Dr Torres would ask why! |
| Glypican-3 | Dr Torres would ask why! |
|
|---|
|
| HBME-1 to IgM |
|---|
| Test | Result |
|---|
| HBME-1 | Dr Torres would ask why! |
| HBV core | Dr Torres would ask why! |
| HBV surface | Dr Torres would ask why! |
| H-caldesmon | Dr Torres would ask why! |
| HCG | Dr Torres would ask why! |
| Helicobacter | Dr Torres would ask why! |
| Hepatocyte | Dr Torres would ask why! |
| HER2/neu | Dr Torres would ask why! |
| HHV-8 | Dr Torres would ask why! |
| HMB-45 | Dr Torres would ask why! |
| HNF1beta | Dr Torres would ask why! |
| HPV | Dr Torres would ask why! |
| HSV-I | Dr Torres would ask why! |
| HSV-II | Dr Torres would ask why! |
| IDH-1 | NEGATIVE |
| Inhibin | Dr Torres would ask why! |
| INI1 (BAF47) | |
| Insulin | Dr Torres would ask why! |
| Kappa | Dr Torres would ask why! |
| Ki-67 | 40% |
| Lambda | Dr Torres would ask why! |
| Leu 7 | Dr Torres would ask why! |
| IgA | Dr Torres would ask why! |
| IgG | Dr Torres would ask why! |
| IgM | Dr Torres would ask why! |
|
|---|
|
| LH to PDGFR |
|---|
| Test | Result |
|---|
| LH | Dr Torres would ask why! |
| LIN28 | Dr Torres would ask why! |
| Lysozyme | Dr Torres would ask why! |
| mammoglobin | Dr Torres would ask why! |
| MAP2 | POSITIVE |
| MCV | Dr Torres would ask why! |
| Melanin A | Dr Torres would ask why! |
| MHC class I | Dr Torres would ask why! |
| MITF | Dr Torres would ask why! |
| MUM1 | Dr Torres would ask why! |
| Myeloperoxidase | Dr Torres would ask why! |
| MYO D1 | Dr Torres would ask why! |
| Myoglobin | Dr Torres would ask why! |
| Napsin | Dr Torres would ask why! |
| NF | Dr Torres would ask why! |
| NKX3.1 | Dr Torres would ask why! |
| NSE | Dr Torres would ask why! |
| OCT3/4 | Dr Torres would ask why! |
| p16 | Dr Torres would ask why! |
| P501S | Dr Torres would ask why! |
| p53 | Dr Torres would ask why! |
| p57 | Dr Torres would ask why! |
| p63 | Dr Torres would ask why! |
| Pankeratin | POSITIVE |
| PAX2 | Dr Torres would ask why! |
| PAX5 | Dr Torres would ask why! |
| PAX8 | Dr Torres would ask why! |
| PCNA | Dr Torres would ask why! |
| PDGFR | Dr Torres would ask why! |
|
|---|
|
| PLAP to WT1 |
|---|
| Test | Result |
|---|
| PLAP | Dr Torres would ask why! |
| PNL-2C | Dr Torres would ask why! |
| Prolactin | Dr Torres would ask why! |
| PSA | Dr Torres would ask why! |
| PSAP | Dr Torres would ask why! |
| RCC | Dr Torres would ask why! |
| S-100 | POSITIVE |
| SALL4 | Dr Torres would ask why! |
| Smooth muscle actin | POSITIVE |
| Somatostatin | Dr Torres would ask why! |
| STAT6 | Dr Torres would ask why! |
| Synaptophysin | POSITIVE |
| TdT | Dr Torres would ask why! |
| TFE3 | Dr Torres would ask why! |
| TFEB | Dr Torres would ask why! |
| Thyroglobulin | Dr Torres would ask why! |
| Toxoplasma | Dr Torres would ask why! |
| TSH | Dr Torres would ask why! |
| TTF-1 | Dr Torres would ask why! |
| Ubiquitin | Dr Torres would ask why! |
| UCHL1 (PGP9.5) | Dr Torres would ask why! |
| Ulex Europaeus | Dr Torres would ask why! |
| Vimentin | POSITIVE |
| VIP | Dr Torres would ask why! |
| VZV | Dr Torres would ask why! |
| WT-1 | Partially positive in the cytoplasm |
|
|---|
|
Molecular testing
Chromosomal translocations
| Translocations Chr 1-10 |
|---|
| Test | Result |
|---|
| t(1;13) PAX7-FKHR | Dr Torres would ask why! |
| t(2,13) PAX3-FKHR | Dr Torres would ask why! |
| t(8;14) MYC-IGH | Dr Torres would ask why! |
| t(9;22) BCR-ABL | Dr Torres would ask why! |
| t(9;22) CHN-EWS | Dr Torres would ask why! |
|
|---|
|
| Translocations Chr 11-13 |
|---|
| Test | Result |
|---|
| t(11;14) CCND1-IGH | Dr Torres would ask why! |
| t(11;22) EWS-WT1 | Dr Torres would ask why! |
| t(11;22) FLI1-EWS | Dr Torres would ask why! |
| t(12;15) ETV6-NTRK3 | Dr Torres would ask why! |
| t(12;16) FUS-ATF1 | Dr Torres would ask why! |
| t(12;16) CHOP-TLS | Dr Torres would ask why! |
| t(12;22) EWS-ATF1 | Dr Torres would ask why! |
|
|---|
|
| Translocations Chr 14-22 |
|---|
| Test | Result |
|---|
| t(14,18) IGH-BCL2 | Dr Torres would ask why! |
| t(15;17) PML-RARA | Dr Torres would ask why! |
| t(16;21) FUS-ERG | Dr Torres would ask why! |
| t(17;22) COLA1-PDGFB | Dr Torres would ask why! |
| t(21;22) EWS-ERG | Dr Torres would ask why! |
|
|---|
|
| Translocations Chr X & Y |
|---|
| Test | Result |
|---|
| t(X;1) PRCC-TFE3 | Dr Torres would ask why! |
| t(X;17) TFE3-ASPL | Dr Torres would ask why! |
| t(X;18) SYT-SSX | Dr Torres would ask why! |
|
|---|
|
Other molecular tests
| Molecular tests (A-B) |
|---|
| Test | Result |
|---|
| ALK sequencing | Dr Torres would ask why! |
| B cell clonality Southern / PCR | Dr Torres would ask why! |
| BCL2 PCR | Dr Torres would ask why! |
| BRAF sequencing | Dr Torres would ask why! |
|
|---|
|
| Molecular tests (C-H) |
|---|
| Test | Result |
|---|
| EBV PCR | Dr Torres would ask why! |
| EGRF sequencing | Dr Torres would ask why! |
| H3F3A sequencing | Dr Torres would ask why! |
| HHV-8 PCR | Dr Torres would ask why! |
|
|---|
|
| Molecular tests (I-J) |
|---|
| Test | Result |
|---|
| Identity testing PCR | Dr Torres would ask why! |
| IDH1/2 PCR | NEGATIVE |
| JAK2 V617F ARMS | Dr Torres would ask why! |
|
|---|
|
| Molecular tests (K-Z) |
|---|
| Test | Result |
|---|
| KIT sequencing | Dr Torres would ask why! |
| LOH 1p/19q PCR | Dr Torres would ask why! |
| T cell clonality Southern / PCR | Dr Torres would ask why! |
|
|---|
|
Diagnosis
Diagnosis
|
|
Atypical teratoid / rhabdoid tumor, WHO grade IV
|
Other cases
|
|---|
| | Number | |
|---|
| Subspecialty
(Difficulty) |
Autopsy pathology (jr,sr, f/e)
Breast pathology (jr,sr, f/e)
Cardiovascular pathology (jr,sr, f/e)
Cytopathology (jr,sr, f/e)
Dermatopathology (jr,sr, f/e)
Endocrine pathology (jr,sr, f/e)
Forensic pathology (jr,sr, f/e)
Gastrointestinal pathology (jr,sr, f/e)
Genitourinary pathology (jr,sr, f/e)
Gynecologic pathology (jr,sr, f/e)
Hematopathology (jr,sr, f/e)
Head and neck pathology (jr,sr, f/e)
Lymph node pathology (jr,sr, f/e)
Medical kidney pathology (jr,sr, f/e)
Molecular pathology (jr,sr, f/e)
Neuropathology (jr,sr, f/e)
Pediatric pathology (jr,sr, f/e)
Pulmonary pathology (jr,sr, f/e)
Placental pathology (jr,sr, f/e)
Soft tissue pathology (jr,sr, f/e) |
|---|
| | Difficulty | |
|---|
|